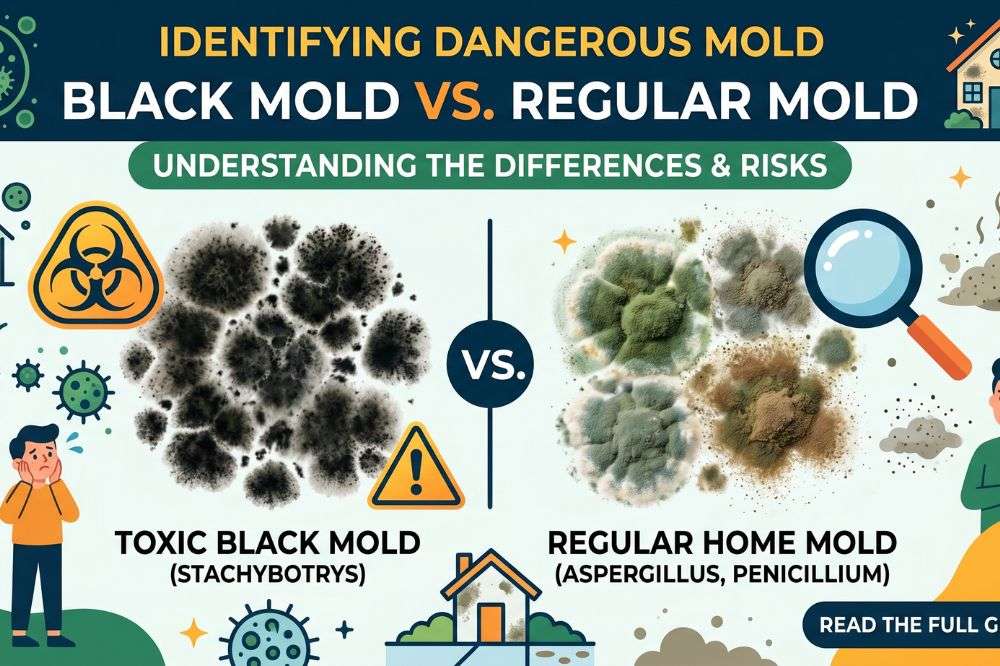
Black Mold vs Regular Mold

Black mold is one of the most misunderstood — and concerning — household hazards. Often hidden behind walls, under flooring, or in damp basements, black mold can negatively impact indoor air quality, damage building materials, and trigger a wide range of health symptoms if left unchecked. This guide explores what black mold is, why it’s hazardous, how to detect it early, and the safest methods for removing and preventing it.
What Is Black Mold?
“Black mold” is a general term used to describe several dark-colored mold species found indoors. One of the most commonly referenced species is Stachybotrys chartarum, which thrives on cellulose-rich materials such as drywall, wood, and paper when moisture is present for prolonged periods.
It’s important to note that not all black-colored mold is toxic, but all indoor mold growth indicates a moisture problem that must be corrected. According to Healthline’s explanation of black mold exposure, mold spores are naturally present in the air, but they become a problem when they settle and multiply in damp environments, leading to visible growth and airborne contamination.
Why Black Mold Is Dangerous
Health Risks of Black Mold Exposure
Exposure to black mold can cause a variety of health effects, particularly for sensitive individuals. TheCenters for Disease Control and Prevention (CDC) mold health guidelines confirm that indoor mold exposure can cause respiratory irritation, allergic reactions, and worsening asthma symptoms.
Common health effects include:
- Persistent coughing or wheezing
- Nasal congestion and sinus irritation
- Eye, throat, and skin irritation
- Headaches and fatigue
- Asthma flare-ups
- Increased respiratory infections
According to Cleveland Clinic’s medical overview of black mold, individuals with compromised immune systems, those with chronic lung conditions, infants, and elderly adults are especially vulnerable to mold-related health complications.
For a deeper breakdown of symptoms and long-term risks, visit our in-depth resource on the health effects of indoor mold exposure.
How Black Mold Develops in Homes
Black mold does not appear overnight. It develops when moisture remains unresolved. The Environmental Protection Agency’s mold growth guidance states that mold can begin growing within 24–48 hours after water exposure.
Common causes include:
- Roof leaks or plumbing failures
- Flooding or storm damage
- Poor bathroom or kitchen ventilation
- High indoor humidity
- Damp basements or crawl spaces
- Condensation buildup on windows or HVAC systems
If moisture is not controlled, mold can spread rapidly behind walls, beneath flooring, and inside insulation.
Signs You May Have Black Mold
Visual Indicators
Black mold often appears as dark green or black patches that may look fuzzy, slimy, or soot-like. According to the Institute for Energy and Environmental Research, mold growth is frequently accompanied by water stains, peeling paint, or warped drywall.
Odor Clues
A persistent musty or earthy smell is often one of the earliest indicators of hidden mold growth.
Health Symptoms Indoors
The CDC’s mold exposure guidance notes that worsening symptoms indoors and improvement outdoors may point to indoor mold contamination.
How Mold Is Properly Identified
Although DIY mold test kits are widely sold, the CDC advises against routine air testing because results are often inconsistent. Instead, professional inspections rely on:
- Visual assessments
- Moisture detection tools
- Identification of water intrusion sources
- Determining contamination spread
If mold is visible, testing is usually unnecessary — remediation should begin immediately.
Is Black Mold Always Toxic?
There is widespread misinformation suggesting black mold is universally deadly. According to the Cleveland Clinic’s medical review, there is no conclusive evidence that household mold exposure causes cancer or systemic poisoning in healthy individuals. However, prolonged exposure can significantly worsen respiratory and immune-related conditions.
Safe Mold Removal: What Works and What Doesn’t
When DIY Cleanup Is Acceptable
The EPA’s mold cleanup recommendations state that mold covering less than 10 square feet can often be safely handled by homeowners with proper protective equipment.
Key steps include:
- Fixing the moisture source first
- Wearing gloves, eye protection, and an N95 respirator
- Cleaning non-porous surfaces with approved cleaners
- Thoroughly drying the area after cleanup.
When Professional Mold Removal Is Necessary
Professional remediation is strongly recommended when:
- Mold exceeds 10 square feet.
- Mold is hidden inside walls or HVAC systems.
- Water damage was extensive.
- Mold repeatedly returns
- Occupants have respiratory or immune conditions.
For expert assistance, visit our professional mold removal services in Washington State to ensure safe, thorough remediation.
Preventing Black Mold From Returning
According to Healthline’s mold prevention guidance and the EPA’s moisture control recommendations, effective prevention includes:
- Keeping indoor humidity below 50%
- Repairing leaks immediately
- Using exhaust fans in bathrooms and kitchens
- Installing dehumidifiers in basements
- Ensuring proper drainage around foundations
- Drying wet materials within 24–48 hours
Final Thoughts
Black mold should never be ignored or masked with surface cleaning alone. It signals an underlying moisture issue that can affect both human health and structural integrity. Early detection, proper remediation, and professional support when needed are the most effective ways to protect your home.
If you suspect mold growth, taking action now can prevent far more costly repairs and long-term health concerns later.